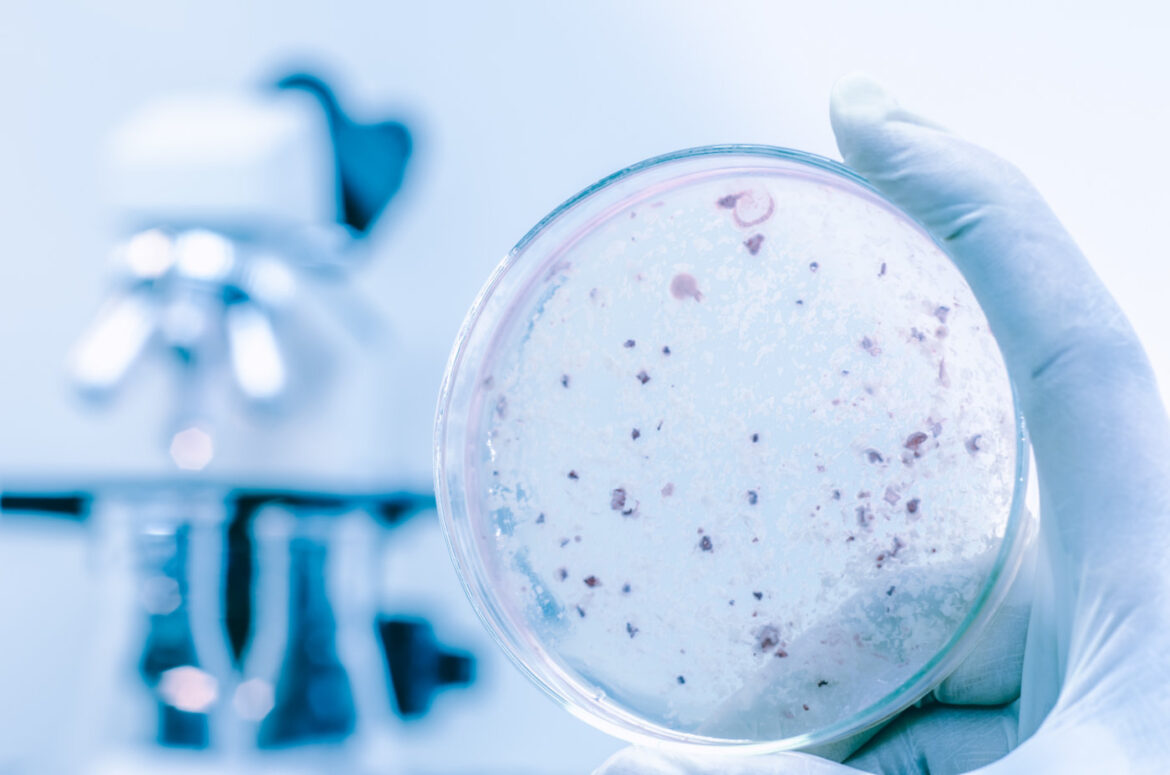

İçme suyu vasıtası ile bulaşabilen hastalıklar arasında tifo, paratifo, basili dizanteri, kolera, amibli dizanteri, lejyonerler hastalığı, sarılık, çocuk felçi gibi hastalıklar vardır. Bu hastalıklara sebep olan mikroorganizmaların suda düzenli olarak ölçülmesi zor ve masraflıdır. Bu sebeple suyun mikrobiyolojik kalitesi indikatör (gösterge) organizmaların konsantrasyonları ölçülerek tespit edilir.
Bunun için en yaygın olarak kullanılan organizma koliform bakterileridir. Koliform bakterisinin kendisi hastalık yapan bir mikroorganizma sayılmamakla beraber suda bulunması zararlı organizmaların varlığına da işaret eder. Suda koliform yoksa diğer organizmaların da olmadığı kabul edilir. Ayrıca koliform konsantrasyonu dezenfeksiyon işleminin ne derecede başarılı olduğunu takip etmek için ölçülür.
Koliform bakterilerini etkili bir şekilde gideren arıtma işlemlerinin hastalık yapan organizmaları da yok ettiği (sudan ayırdığı veya öldürdüğü) düşünülür. İçme suyu tesis çıkışlarında ve su şebekesindeki numune alma yerlerinde çeşitli aralıklarla alınan numunelerde bulunmasına müsaade edilen koliform miktarı ile ilgili çeşitli kural ve standartlar vardır. Bu tür standartlar her ülkede değişik olabildiği gibi herhangi bir ülkede zamanla da değişebilmektedir. En genel ve en basit ifadesi ile, içme suyunda toplam koliform konsantrasyonunun sıfır olması tavsiye edilir.
Sağlık açısından emniyetli ve içilebilir bir su aşağıdaki özelliklere sahip olmalıdır:
- Suda hastalık yapan (patojenik) mikroorganizmalar olmamalıdır.
- Kurşun gibi zehirli veya uzun vadede sağlığa zararlı etkileri olan maddelerin konsantrasyonları belli sınırlar altında olmalı veya bunlar hiç bulunmamalıdır.
- Berrak ve renksiz olmalıdır.
- Tuzlu olmamalıdır.
- Rahatsız edici koku ve tadlar bulunmamalıdır.
- Ekonomik zararlara sebep olacak kadar sert (“kireçli”) olmamalıdır.
- Agresif (aşındırıcı/korrosif) olmamalıdır.
Göl, nehir, kuyu gibi su kaynaklarından elde edilen sular her zaman bu özelliklerin hepsine birden sahip değildir. Herhangi bir kaynakdan elde edilen ve henüz arıtılmamış bir su için ‘ham su’ tabiri kullanılır. Su arıtma metodlarını anlamak için öncelikle suyun kalitesini tayin eden parametreler hakkında bilgi sahibi olmak gerekir.